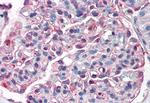
ZIP14 Antibody in Immunohistochemistry (Paraffin) (IHC (P))

Search
Invitrogen
ZIP14 Polyclonal Antibody
{{$productOrderCtrl.translations['antibody.pdp.commerceCard.promotion.promotions']}}
{{$productOrderCtrl.translations['antibody.pdp.commerceCard.promotion.viewpromo']}}
{{$productOrderCtrl.translations['antibody.pdp.commerceCard.promotion.promocode']}}: {{promo.promoCode}} {{promo.promoTitle}} {{promo.promoDescription}}. {{$productOrderCtrl.translations['antibody.pdp.commerceCard.promotion.learnmore']}}

Please note: We are reviewing Western blot images included in the antibody testing data in our catalog, including those provided by third parties. Unless expressly labeled or annotated as “raw-unedited”, Western blot images included in the antibody testing data in our catalog may have been edited, optimized or otherwise adjusted for presentation.
产品信息
PA5-33033
种属反应
宿主/亚型
分类
类型
抗原
偶联物
形式
浓度
规格
纯化类型
保存液
内含物
保存条件
运输条件
RRID
产品详细信息
Percent identity with other species by BLAST analysis: Human, Gorilla, Orangutan, Gibbon, Monkey, Marmoset, Hamster (100%) Bovine, Horse, Opossum (94%).
靶标信息
The zinc transporter ZIP14, also known as SLC39A14, is a member of a family of divalent ion transporters. Zinc is an essential ion for cells and plays significant roles in the growth, development, and differentiation. The zinc transporter family is divided into four subfamilies (I, II, LIV-1 and gufA). ZIP14 is a glycosylated multipass plasma membrane protein that belongs to the ZIP transporter subfamily LIV-1. ZIP14 has been shown to contribute to the hypozincemia of inflammation and infection and is regulated in the liver by IL-6. In addition to zinc, ZIP14 is also involved in the cellular uptake of non-transferrin-bound iron as well as iron bound to transferrin.
仅用于科研。不用于诊断过程。未经明确授权不得转售。
篇参考文献 (0)
生物信息学
蛋白别名: LIV-1 subfamily of ZIP zinc transporter 4; LZT-Hs4; Metal cation symporter ZIP14; solute carrier family 39 (zinc transporter), member 14; Solute carrier family 39 member 14; Zinc transporter ZIP14; ZIP-14; Zrt- and Cig19; Zrt- and Irt-like protein 14
基因别名: KIAA0062; SLC39A14; ZIP14
Entrez Gene ID: (Chinese hamster) 100768099



